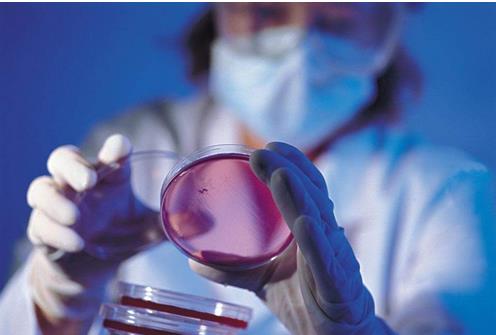

2017“q┤µ¢░“q┤õ╝ŖÕ¦ŗ’╝īµ¢░µØɵ¢Öõ±öõĖÜÕŹ│õ╝ĀÕć║ķćŹĶ”üÕł®ÕźĮµČłµü»ŌĆöŌĆ?016“q?2µ£?8µŚźõĖŁÕøĮµö┐Õ║£ńĮæÕģ¼ÕĖāÕQīõžōĶ┤»ÕĮ╗Õ«×µ¢ĮÕłēÖĆĀÕ╝║ÕøĮµłśńĢź’╝īÕŖĀÕ┐½µÄ©Ķ┐øµ¢░µØɵ¢Öõ±öõĖÜÕÅæÕ▒Ģ’╝īÕøĮÕŖĪķÖóÕå│իܵłÉń½ŗÕøĮÕ«Čµ¢░µØɵ¢Öõ║¦õĖÜÕÅæÕ▒ĢķóåÕ»╝׫Åń╗äÕQīĶ┤¤Ķ┤ŻÕ«ĪĶ««µÄ©ÕŖ©µ¢░µØɵ¢Öõ║¦õĖÜÕÅæÕ▒ĢńÜäµĆųMĮōķā©ńųvŃĆüķćŹĶ”üĶ¦äÕłÆ’╝īŠl¤ńŁ╣ńĀöń®ČķćŹÕż¦µö┐ńŁ¢ŃĆüķćŹÕż¦ÕĘźĮEŗÕÆīķćŹĶ”üÕĘźõĮ£Õ«ēµÄÆŃĆ?

2017“q┤µ¢░µØɵ¢Öõ║¦õĖÜÕÅæÕ▒Ģ׫åÕ╝ĆÕÉ»µ¢░ÕŠüń©ŗ
ÕøĮÕŖĪķÖóÕē»µĆ╚ØÉåķ®¼Õ滵ŗģõōQŠläķĢ┐ÕQīÕĘźõĖÜÕÆīõ┐Īµü»Õī¢ķā©ķā©ķĢ┐ĶŗŚÕ£®ÕÆīÕøĮĶĄäÕ¦öõĖųMōQĶé¢õ║ÜÕ║åńŁēµŗģõōQÕē»ń╗äķĢÄņĆöŌĆöÕ”éµŁżÕ╝║Õż¦ńÜäķśĄÕ«╣ÕQīµäÅÕæ│ńØĆÕģÜõĖŁÕż«ŃĆüÕøĮÕŖĪķÖóķ½śÕ║”ķćŹĶ¦åµ¢░µØɵ¢Öõ±öõĖÜÕÅæÕ▒Ģ’╝īµØɵ¢ÖÕ¤║ńĪƵƦŃĆüÕģłÕ»╝µĆ¦õĮ£ńö©ĶÄĘÕŠŚÕ╣┐µ│øĶ«żÕÉī’╝īŌĆ£µØɵ¢ÖÕģłĶĪīŌĆصĖɵłÉõĖÜńĢīÕģ▒Ķ»å’╝īµ¢░µØɵ¢ÖÕ£©ÕøĮÕ«ČÕłøµ¢░ķ®▒ÕŖ©ÕÅæÕ▒ĢµłśńĢźõĖŁńÜäÕłåķćÅŁæŖµØźŁæŖķćŹŃĆüÕ£░õĮŹĶČŖµØźĶČŖķćŹĶ”üŃĆ?br />
2017“q▀_╝īµ¢░µØɵ¢Öõ±öõĖÜńÜäÕÅæÕ▒ĢÕĆ╝ÕŠŚµ£¤ÕŠģŃĆéÕ£©µö┐ńŁ¢Õ▒éķØóÕQīµ£ēµ£øÕŠŚÕł░µø┤ÕżÜµēȵīüŃĆéõĖÜńĢīõØhÕŻ½Õģ│µ│©ńÜäŃĆŖµ¢░µØɵ¢ÖÕÅæÕ▒ĢĶ¦äÕłÆµīćÕŹŚŃĆŗ’╝īńö▒ÕĘźõ┐Īķā©ĶĄ»éŹēÕQīµś»ÕÉ”ĶāĮÕ£©µ¢░ńÜäõĖĆ“q┤Õć║ÕÅ?
µīćÕŹŚµ£ēµ£øĶ»ĀķćŖÕQīµ¢░µØɵ¢ÖķóåÕ¤¤ńÜäÕÅæÕ▒ĢķćŹńéęÄ(gu©®)ś»ńē╣ń¦ŹµŚĀµ£║ķØ×ķćæÕ▒×µØɵ¢ÖŃĆüÕģłśqøÕżŹÕÉłµØɵ¢ÖŃĆüńē╣┐UŹķćæÕ▒×ÕŖ¤ĶāĮµØɵ¢ÖŃĆüķ½śµĆ¦ĶāĮŠlōµ×äµØɵ¢ÖŃĆüÕŖ¤ĶāĮµĆ¦ķ½śÕłåÕŁÉµØɵ¢ÖŃĆéĶ”üÕŖĀÕ┐½ńĀöÕÅæÕģłĶ┐øńåöńé╝ŃĆüÕćØÕø║µłÉÕ×ŗŃĆüµ░öńøĖµ▓ē┐U»ŃĆüÕ×ŗµØÉÕŖĀÕĘźŃĆüķ½śµĢłÕÉłµłÉńŁēµ¢░µØɵ¢ÖÕłČÕżćÕģ│ķö«µŖƵ£»ÕÆīĶŻģÕżćÕQīÕŖĀÕ╝║Õ¤║╝ŗĆńĀöń®ČÕÆīõĮōŠpšdŠÅĶ«Š’╝īĮHüńĀ┤õ║¦õĖÜÕī¢ÕłČÕżćńōČķółŃĆéń¦»µ×üÕÅæÕ▒ĢÕåøµ░æÕģ▒ńö©ńē╣┐UŹµ¢░µØɵ¢ÖÕQīÕŖĀÕ┐½µŖƵ£»ÕÅīÕÉæĶØ{┐U╗ĶØ{Õī¢’╝īõ┐āĶ┐øµ¢░µØɵ¢Öõ±öõĖÜÕåøµ░æĶ׏ÕÉłÕÅæÕ▒ĢŃĆ?br />
ÕÅ”õĖĆõĖ¬ÕĆ╝ÕŠŚÕ»åÕłćÕģŽx│©ńÜäµö┐Į{¢’╝īµś»µ¢░µØɵ¢ÖŌĆ£ÕŹüõĖēõ║öŌĆØĶ¦äÕłÆ’╝īńø«ÕēŹŠ~¢ÕłČÕĘ▓Õ¤║µ£¼ń╗ōµØ¤’╝īµ£ēµ£øśqæµŚźÕć║ÕÅ░ŃĆéµ£¬µØźĶ”üķćŹńé╣ĮHüńĀ┤µ¢░µØɵ¢ÖÕ║öńö©ńōČķółńÜäÕłČń║”ŃĆéµ¢░µØɵ¢Öõ║¦õĖÜŌĆ£ÕŹüõĖēõ║öŌĆØĶ¦äÕłÆÕ░åõ╗ÄÕŹćŠU¦Õ¤║╝ŗƵØɵ¢ÖŃĆüÕÅæÕ▒ĢµłśńĢźµØɵ¢Öõ╗źÕÅŖķü┤ķĆēÕēŹµ▓┐µ¢░µØɵ¢ÖõĖēõĖ¬Õ▒éķØóÕć║ÕÅæÕQīÕ»╣ŌĆ£ÕŹüõĖēõ║öŌĆص£¤ķŚ┤µłæÕøĮµ¢░µØɵ¢Öõ║¦õĖÜÕÅæÕ▒ĢõĮ£Õć║ŠlåĶć┤Ķ¦äÕłÆŃĆéÕģČńø«ńÜ䵜»õ┐āõĮ┐µłæÕøĮµ¢░µØɵ¢Öõ║¦õĖܵĢ┤õĮōÕŹćń±öÕQīõžōÕłēÖĆĀõĖÜÕÆīÕ«×õĮōń╗Åŗ╣ÄÕÅæÕ▒ĢÕźĀÕ«Üõ±öõĖÜÕ¤║╝ŗĆ;ÕÉīµŚČķĆÜĶ┐ćµ¢░µØɵ¢ÖÕŹćŠU¦’╝īÕŖĀÕ┐½ķÆóķōüŃĆüµ£ēĶēīėĆüń¤│Õī¢ŃĆüĶĮ╗ÕĘźŃĆüՊŵØÉŃĆüńØhŠlćńŁēÕ¤║ńĪĆÕłēÖĆĀõĖÜÕÉæõ±öõĖÜõĖŁķ½śń½»śqłĶ┐øÕQīÕŲłõĖ║ÕłČķĆĀõĖܵĢ┤õĮōĶĮ¼Õ×ŗÕŹćń±öÕ»└LēŠÕÉÄń«ŗÕÅæÕ▒ĢńÜäÕÅ»µīüń«ŗÕŖ©ÕŖøŃĆ?br />
µ»ŗÕ║ĖŠ|«ń¢æÕQ?017“q┤µ¢░µØɵ¢ÖķóåÕ¤¤õ║¦õĖÜÕēŹµÖ»Ķē»ÕźĮŃĆéµ¢░µØɵ¢Öµś»ŌĆ£Õ╝║ÕøĮõ╣ŗÕ¤║ŌĆØ’╝īµś»õ┐ØķÜ£õĖŁÕøĮÕłČķĆĀÕ«×ńÄ░ńö▒Õż¦ÕÅśÕ╝║ńÜäńē®Ķ┤©Õ¤║ńĪĆŃĆéÕ»╣õ║ÄՊŵØÉĶĪīõĖÜµØźĶ»▀_╝īÕŖ¬ÕŖøµÄ©Ķ┐øµ¢░µØɵ¢ÖÕÅæÕ▒Ģ’╝īµś»ÕūIĶĪźÕŠÅµØÉÕĘźõĖÜÕÅæÕ▒Ģń¤ŁµØ┐ńÜäÕ┐ģĶ”üõ╣ŗõŗDŃĆéµ¢░ńÜäõĖĆ“q▀_╝īµø┤Õ║öķøåõĖŁÕŖøķćÅõ╝śÕģłÕģŽx│©õ╗źõĖŗµ¢░µØɵ¢Öõ±öÕōü’╝Ü ķ½śµĆ¦ĶāĮŠUżń╗┤ÕÅŖÕżŹÕÉłµØɵ¢ÖŃĆüń¤│Õó©ńā»ÕÅŖÕģȵöęÄ(gu©®)ƦµØɵ¢ÖŃĆüÕĘźõĖÜńÄ╗ńÆāŃĆüÕĘźõĖÜķÖČńōŚ„ĆüõØhÕĘźµÖČõĮōŃĆüń¤┐ńē®ÕŖ¤ĶāĮµØɵ¢ÖŃĆüµ¢░Õ×ŗń╗┐Ķē▓ՊŵØÉŃĆ?br />
ÕĘźõ┐Īķā©ÕĤµØɵ¢ÖÕÅĖÕÅĖķĢ┐Õæ©ķĢ┐ńøŖ2016“q?0µ£?1µŚźÕ£©µ£¼µŖźÕÅæĶĪ©Š|▓ÕÉŹµ¢ćń½ĀµīćÕć║ÕQīõ╗ŖÕÉÄõĖĆīDē|ŚČķŚ┤Ķ”üµŖōõĮŵ£║ķüćÕQīÕØܵīüķŚ«ķóśÕ»╝ÕÉæ’╝īń½ŗĶā÷ÕŹÅÕÉīµÄ©Ķ┐øÕQīĶŖ▒Õż¦ÕŖøµ░öĶĪźĶĪīõĖÜÕÅæÕ▒Ģń¤ŁµØ┐ŃĆ?br />
Õ╗║µØÉĶĪīõĖÜÕ║öĶ»źµø┤Ķ«żĶ»åÕł░ÕÅæÕ▒Ģµ¢░µØɵ¢ÖÕ»╣Õ╗║µØÉÕĘźõĖܵł¬ķĢ┐ĶĪźń¤ŁŃĆüń╗ōµ×äĶ░āµĢ┤ŃĆüÕó×ÕŖĀµ£ēµĢłõŠøŠlÖŃĆüÕŖĀÕ┐½ĶØ{Õ×ŗÕÅæÕ▒Ģ’╝īķü┐ÕģŹķćŹÕżŹÕ╗°Ö«ŠÕÆīµŚĀÕ║Åń½×õ║ēńÜäńŗ¼ńē╣õĮ£ńö©ÕQīÕ╝ĢÕ»╝ÕÅæÕ▒ĢĶ”üń┤ĀÕÉæµ£ēÕ║ŵ¢░µØɵ¢Öõ±öõĖÜĶØ{┐UšdÆīĶüÜķøåÕQīķ╝ōÕŖ▒ÕĘ«Õ╝éÕī¢ÕÅæÕ▒ĢÕQīÕŖ¬ÕŖøµÅÉķ½śÕģ©Ķ”üń┤Āńö¤õ±öńÄćŃĆ?br />
Õ£©µ¢░µØɵ¢ÖķóåÕ¤¤ÕQīµ£¤ÕŠģńØƵø┤ÕżÜõĖōõĖÜõ║║µēŹÕć║ńÄ░ÕQīµø┤µ¢░ÕĖéÕ£║Õ╝ƵŗōĶ¦éÕ┐Ą’╝ī׫ĮÕ┐½õ║åĶ¦Żń夵?zh©©n)ēśqøÕģźńē╣Õ«ÜÕ║öńö©ÕĖéÕ£║µēĆķ£ĆµÄīµÅĪŃĆüķĆÜĶ┐ćńÜäĶ«żĶ»üĶ¦äÕłÖ’╝īńē╣Õł½µś»ķéŻõ║øµ£ēµ£øµ£ŹÕŖĪõ║ÄÕÅæÕ▒ĢµĮ£ÕŖøÕż¦ŃĆüÕĖéÕ£║ń®║ķŚ┤Õ╣┐ńÜäĶł¬ĮI║ŃĆüµĀĖńöļŖŁēķóåÕ¤¤ńÜäõ±öÕōü’╝īńĀöÕłČńö¤õ±öÕŹĢõĮŹõ╗ÄńĀöÕłČńö¤õ║¦õ╣ŗÕłØÕ░▒õĖšdŖ©µīēµēĆĶ”üµ▒éńÜäĶ«żĶ»üĶ¦äÕłÖÕÄ╗Šläń╗ć┐UæńĀöńö¤õ±öĮ{ēµ┤╗ÕŖ©’╝īÕŖ¬ÕŖøÕćÅÕ░æÕÅæÕ▒ĢÕ╝»ĶĄ\ŃĆ?br />
Õ£©õ±öõĖÜÕÉłõĮ£µ¢╣ķØó’╝īõ║”µ£¤ÕŠģĶ┐łÕć║µ¢░ńÜ䵣źõ╝ÉŃĆéõĖŖõĖŗµĖĖÕŖĀÕ╝║ÕÉłõĮ£ÕQīÕŹÅÕÉīÕłøµ¢Ä═╝īµ▓┐ńØĆõ║¦õĖÜķōŠ’╝īµö┐Õ║£×«åµö»µīüÕÉäńÄ»ĶŖéķ¬©Õ╣▓ÕŹĢõĮŹŠläÕŠÅÕł®ńøŖÕģūāĒnķŻÄķÖ®Õģ▒µŗģńÜäõ±öõĖÜÕÅæÕ▒ĢĶüöńø¤’╝īõ╗źÕ«×ńÄ░µ¢░µØɵ¢ÖŠlłµ×üÕ║öńö©õĖ║ńø«µĀć’╝ī“qČõ╗źŠlłµ×üÕ║öńö©õĖ║ķŠÖÕż▀_╝īķććÕÅ¢ŌĆ£õĖƵØĪķŠÖŌĆص©ĪÕ╝Å’╝īÕÉäńÄ»ĶŖéĶüöÕŖ©µö╗Õģ╗I╝īÕģ▒ÕÉīµÄ©Ķ┐øõ║¦Õōüķ”¢µē╣ŗŲ?ķ”¢ÕÅ░Õź?ĮC°ÖīāÕ║öńö©ŃĆ?br />
ķ£Ćµ▒éńēĄÕ╝Ģ’╝īÕĖéÕ£║Õ»╝ÕÉæÕQ?017“q┤µ¢░µØɵ¢Öõ║¦õĖÜÕÅæÕ▒Ģ׫åÕ╝ĆÕÉ»µ¢░ńÜäÕŠüĮEŗŃĆ?µØźµ║ÉÕQÜõĖŁÕøĮÕĪæµ¢Öµ£║µó░ńĮæ)
ÕģŹĶ┤ŻÕŻ░µśÄÕQÜķā©ÕłåĶĄäµ¢ÖµØźµ║Éõ║ÄŠ|æń╗£ÕQīĶØ{ĶĮĮńÜäńø«ńÜäÕ£©õ║Äõ╝ĀķĆƵø┤ÕżÜõ┐Īµü»ÕÅŖÕłåõĒnÕQīÕŲłõĖŹµäÅÕæ│ńØĆĶĄ×ÕÉīÕģČĶ¦éńéęÄ(gu©®)ł¢Ķ»üÕ«×ÕģČń£¤Õ«×µĆ¦’╝ī
õ╣¤õĖŹµ×䵳ÉÕģČõ╗¢Õ╗°Ö««ŃĆéõ╗ģµÅÉõŠøõ║żµĄü“qø_Å░ÕQīõĖŹõĖ║ÕģČńēłµØāĶ┤¤Ķ┤ŻŃĆéÕ”éµČēÕÅŖõŠē|ØāÕQīĶ»ĘĶüöń│╗µłæõ╗¼ÕÅŖµŚČõ┐«µö╣µł¢ÕłĀķÖżŃĆ?br>ķé«ń«▒ÕQÜinfo@polymer.cn